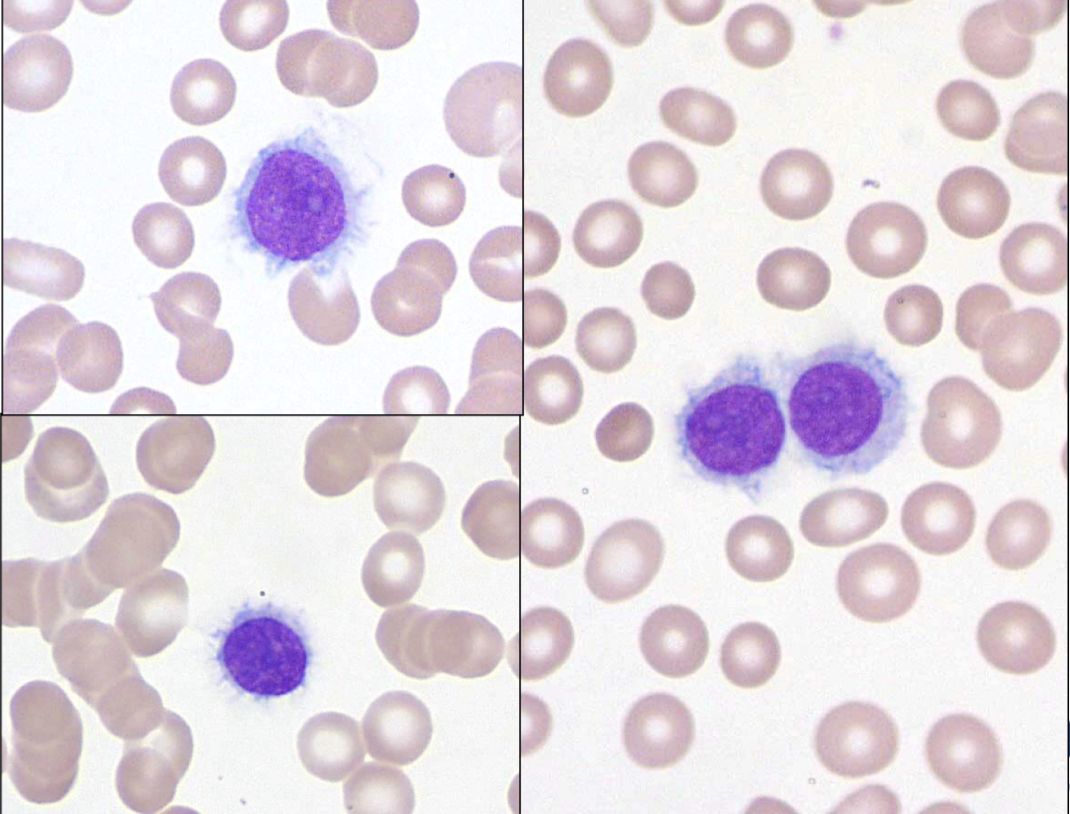
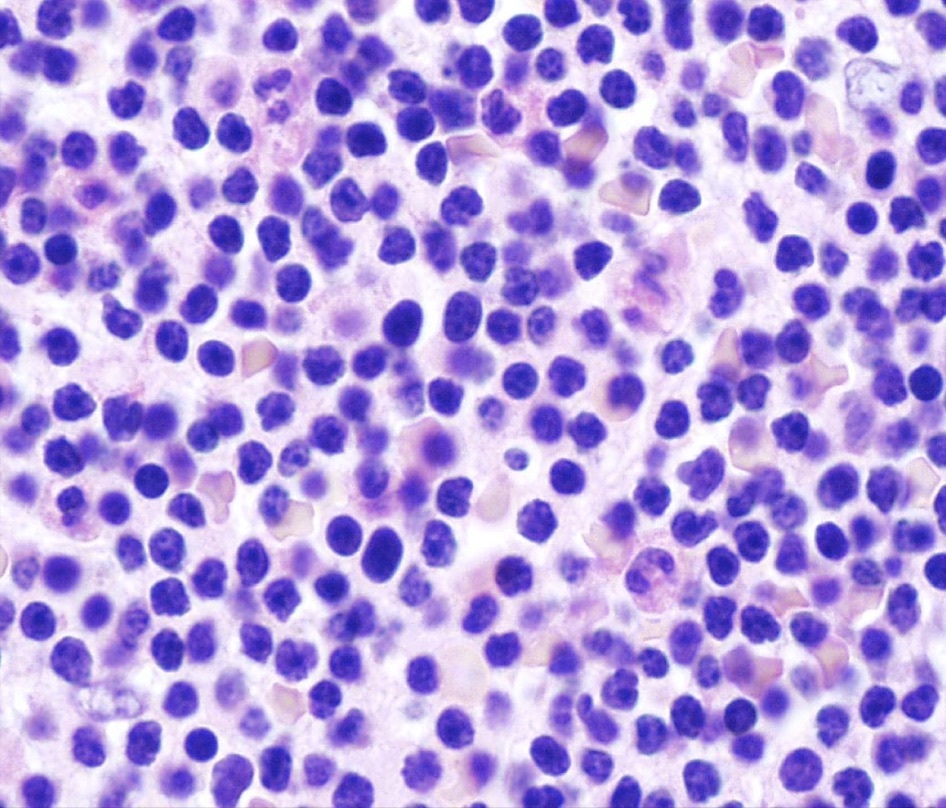
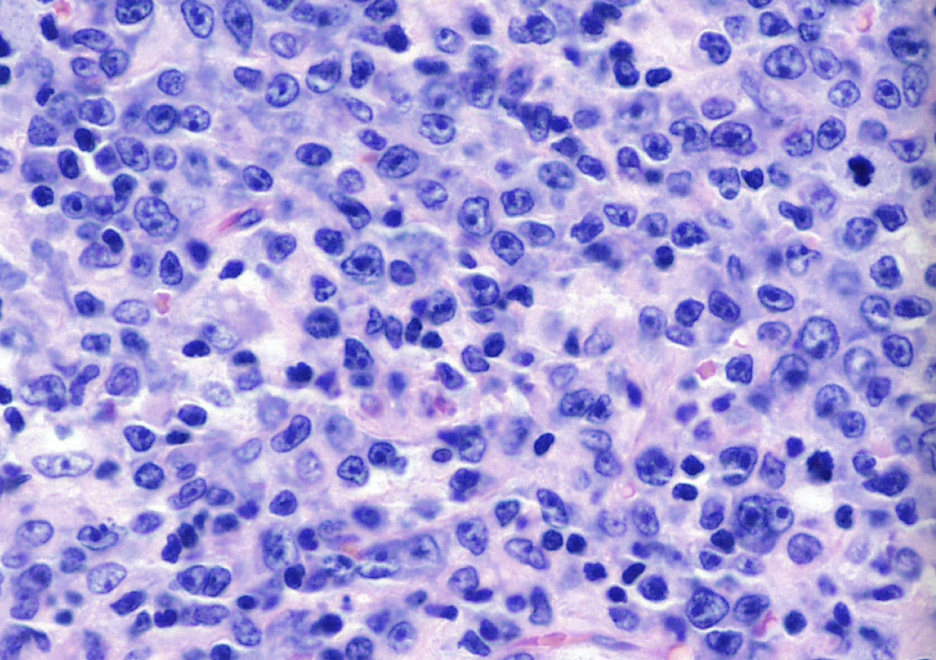
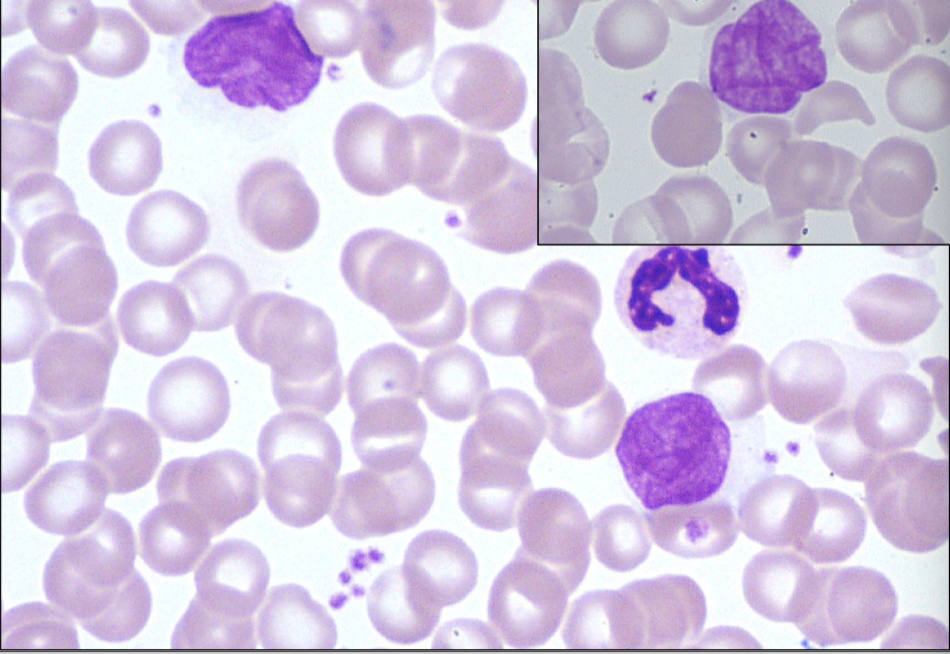
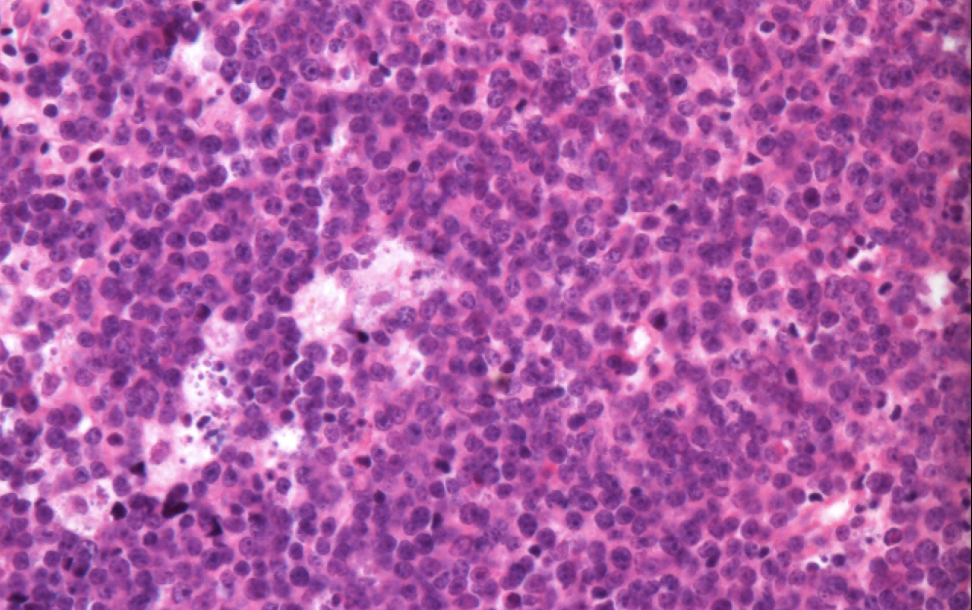
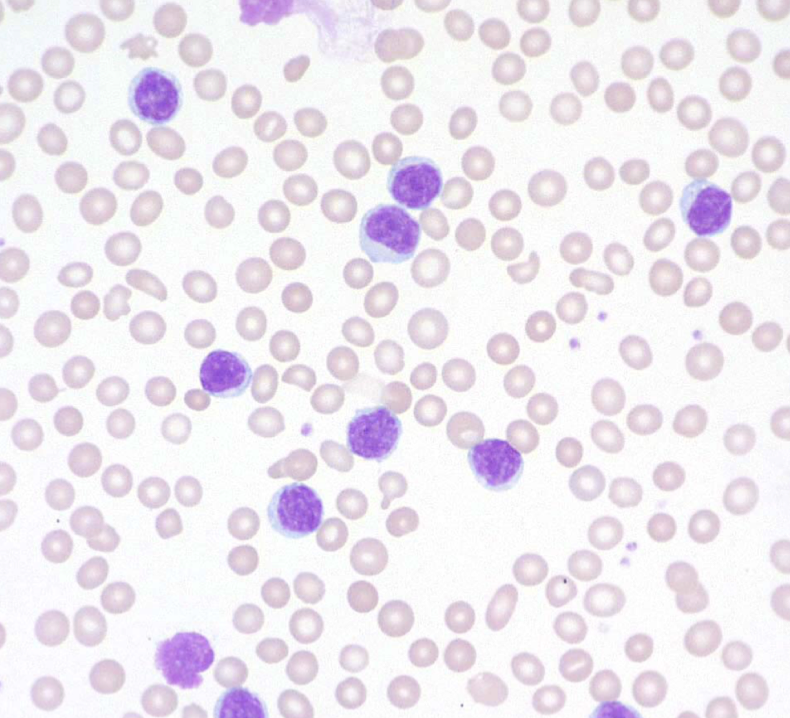
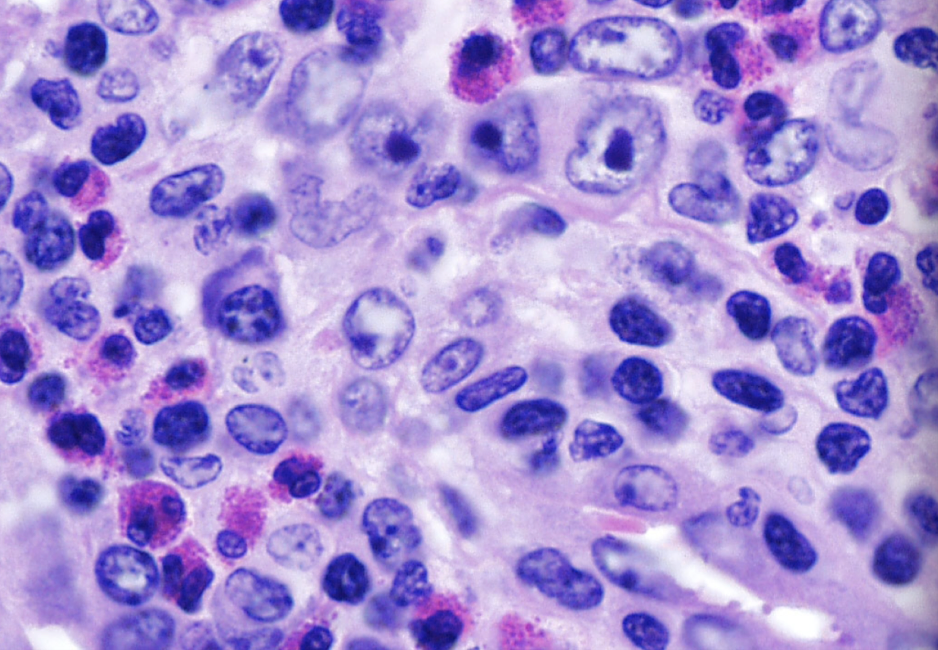
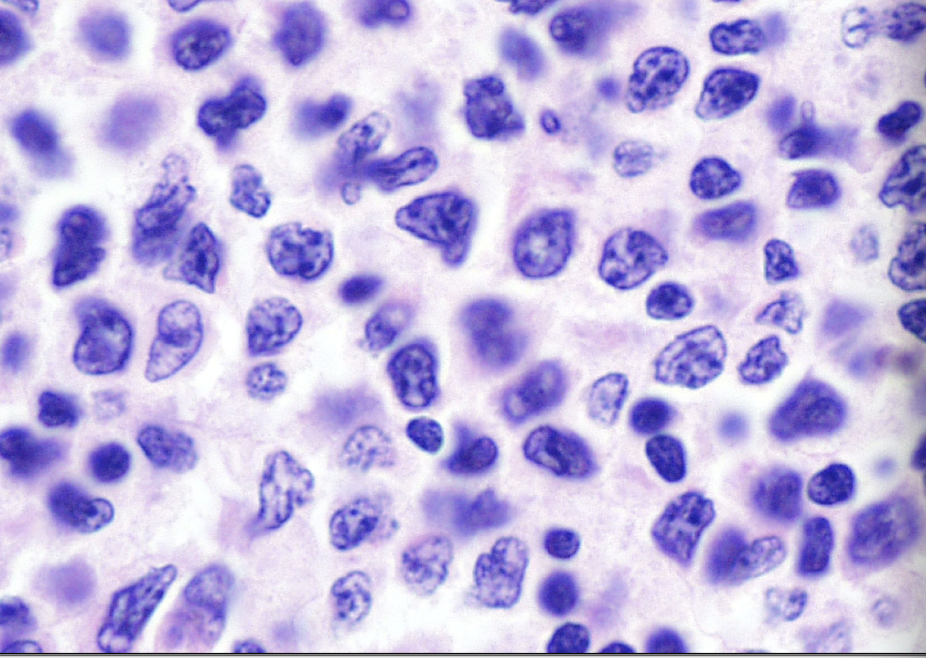
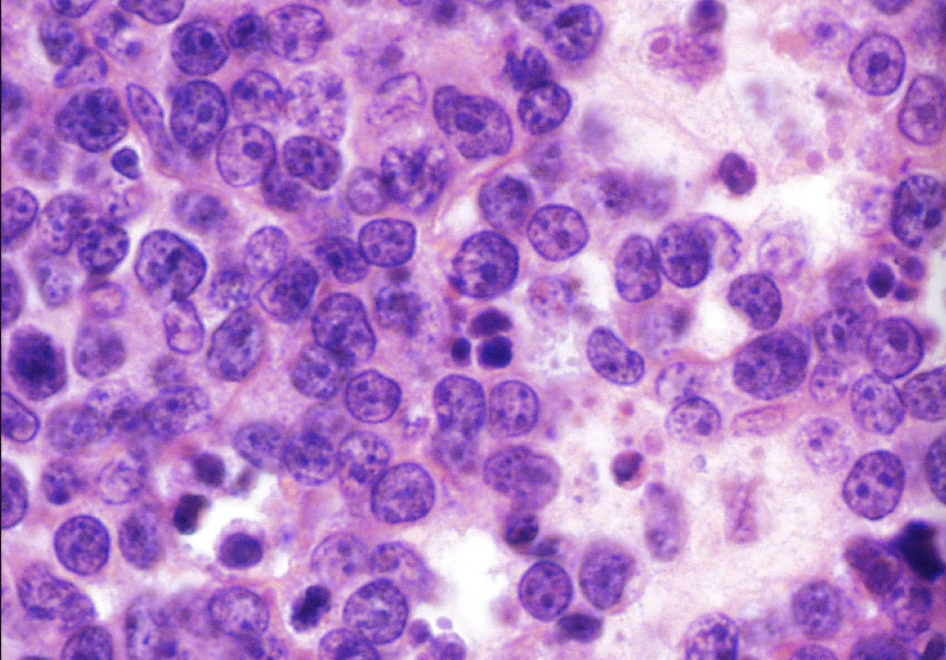
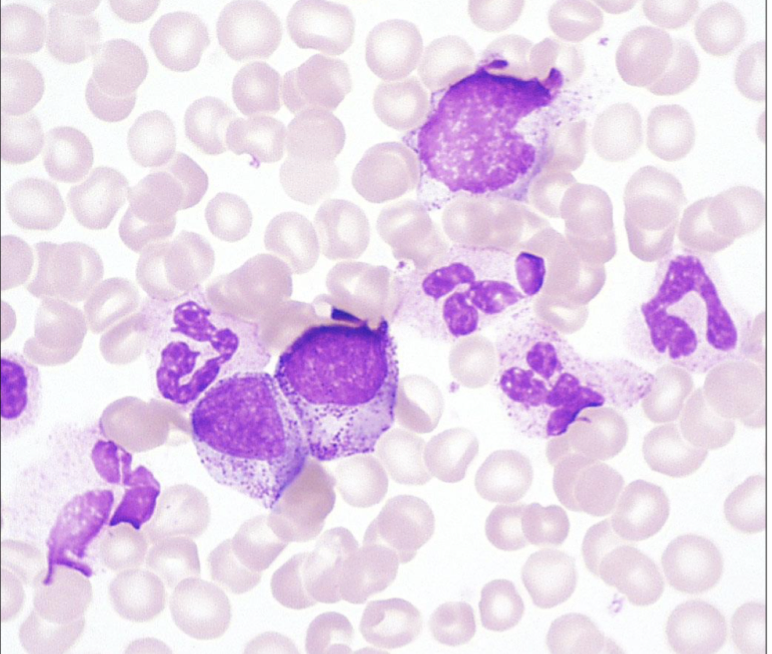
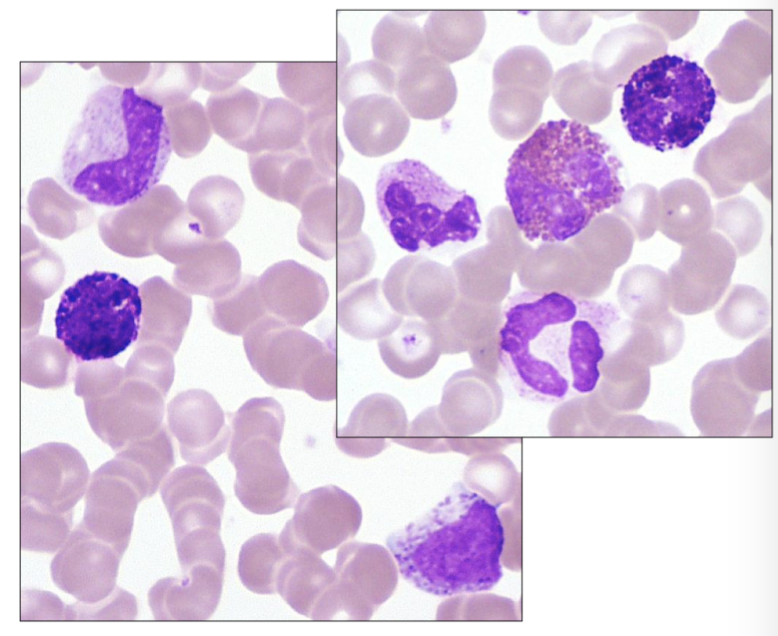
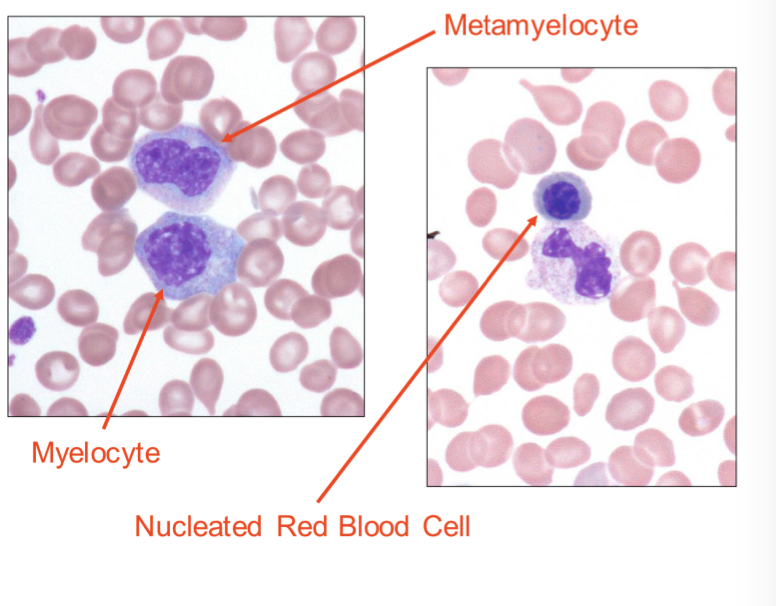
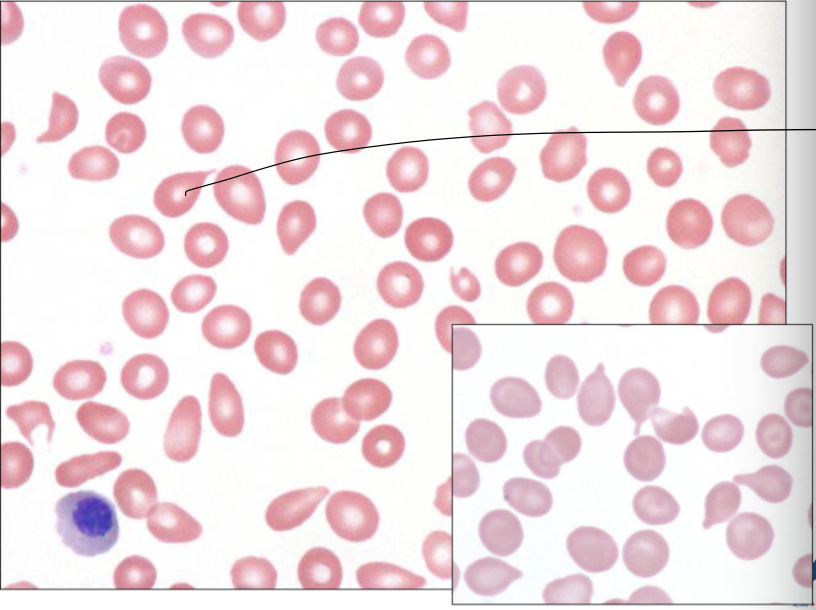

CLL/SLL

Hodgkin Lymphoma

CLL/SLL
Hairy Cell Leukemia
CLL/SLL

Mycosis Fungoides
Diffuse large B cell lymphoma
Sezary Syndrome
“Starry Night” Burkitt Lymphoma

Mycosis Fungoides
Describe the status of CD20,5,10 and other in CLL/SLL, Hairy Cell, MALT, Follicular, Mantle cell

CLL/SLL
Whats the difference bewtween Hodgkins lymphoma and Non-Hodgkin lymphoma?

Hodgkin Lymphoma

Follicular lymphoma
follicular lymphoma
Burkitt Lymphoma
CML
CML

CML

PV

PV
PMF
PMF